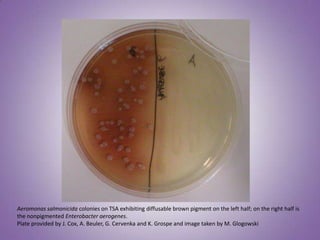
Aeromonas salmonicida colonies on TSA exhibiting diffusable brown pigment on the left half; on the right half is
the nonpigmented Enterobacter aerogenes.
Plate provided by J. Cox, A. Beuler, G. Cervenka and K. Grospe and image taken by M. Glogowski

As bactérias podem causar doenças graves em peixes de cultivo, como a furunculose causada pela bactéria Aeromonas salmonicida e a doença branquial bacteriana causada por Flavobacterium branchiophilum. Estas doenças podem ter altas taxas de mortalidade e são difíceis de tratar, sendo necessário identificar corretamente o agente causador e aplicar antibióticos de forma adequada para controlar surtos e minimizar perdas econômicas.